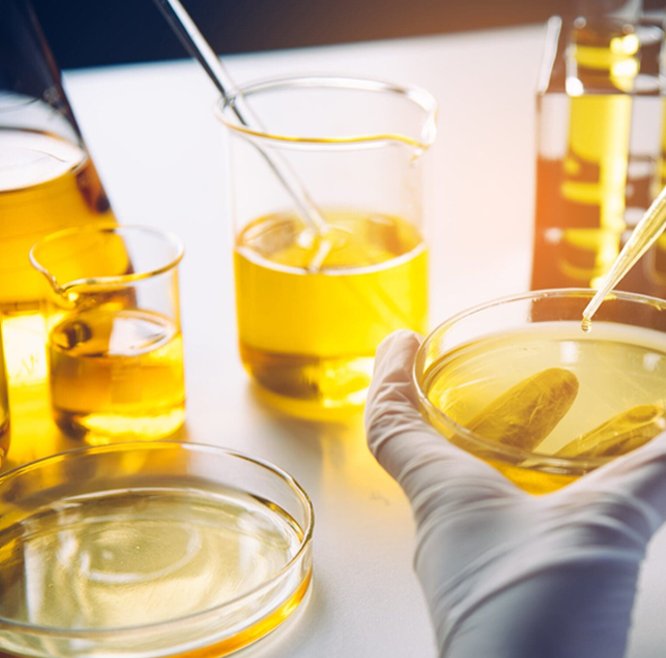

Highly Customizable Design

User
Research

AD
Design

ID
Design

CMF
Design

Brand
Design

Premier Laboratory
Leveraging extensive experience and a "1+3+N" R&D system, we drive innovation in electronic atomization research, development, and production. Our lab offers comprehensive testing in chemistry, aerosol physics, biology, toxicology, atomization, simulation, sensory analysis, reliability, electrical performance, and regulatory safety to ensure product quality and safety.
Strong Manufacturing Support
With the full backing of FirstUnion, Maxcore possesses the industry's most robust factory support system. Our proprietary oversight of the entire ceramic platform manufacturing process ensures unparalleled production capacity and the highest standards of quality.


Absolute Quality Guarantee
At Maxcore, we begin with meticulous quality control planning and design auditing to lay a flawless foundation. Next, every device undergoes rigorous testing, including specialized checks for compatibility with customer oils and real-world user feedback. This leads to our strict final product quality control before any product ships. Our commitment extends beyond our factory, offering on-site guidance for oil filling to ensure perfect product integrity. Finally, our rapid after-sales service guarantees a smooth, supportive partnership long after the sale is complete. This unified process ensures every single device not only meets, but exceeds, the highest standards of performance and reliability.
Real Oil Testing Capabilities
MAXCORE operates two advanced laboratories in the United States and Thailand. Our U.S. lab, established in 2020, specializes in R&D and comprehensive device testing, including longevity, environmental performance, and compatibility. Following three years of preparation, our Thailand lab was officially launched in 2024 to support our global network. Together, these labs leverage the expertise of over 50 skilled professionals from three major research institutes. This dual-lab structure enables us to efficiently serve our global clients while rapidly researching new oil types to maximize flavor and performance.

On-Site Oil Filling Guidance
Our commitment to quality extends to every step of your production process. We provide comprehensive oil filling instructions and the option for hands-on, on-site operational guidance from our technical experts. This ensures a precise and efficient filling process, guaranteeing your final product’s integrity and consistency.
Why Maxcore









